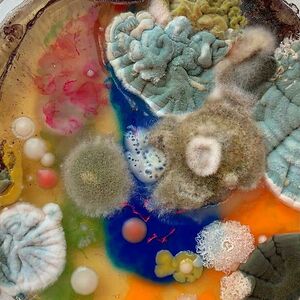

Join the Fun!
Join 1.2 million Panda readers who get the best art, memes, and fun stories every week!
Thank you!
You're on the list! Expect to receive your first email very soon!
Bored Panda is Even Better on the App!
Stay Updated with Real-Time Notifications
Instant Access via Homescreen Tap
Simple Interface - Even Your Cat Can Use It!

dingliusyeeeeeeeeeee
Community Member

1 posts
507 comments
1.1K upvotes
496 points
I'm a fun loving cat who loves hilarious animal and image posts. I'm a gamer with a life, too.

dingliusyeeeeeeeeeee • commented on 33 posts 2 years ago
Show All 33 Comments

dingliusyeeeeeeeeeee • upvoted 7 items 2 years ago

Animals, Dogs
This Man Rescues Dogs In His Area And Decided To Build A Pool For The 27 He Has In His Care
Show All 7 Upvotes

dingliusyeeeeeeeeeee • submitted a new post 2 years ago

dingliusyeeeeeeeeeee • submitted a list addition 2 years ago

dingliusyeeeeeeeeeee • commented on 20 posts 2 years ago

dingliusyeeeeeeeeeee • upvoted 20 items 2 years ago

dingliusyeeeeeeeeeee • is following a person
This Panda has no followers yet

 Dark Mode
Dark Mode 

 No fees, cancel anytime
No fees, cancel anytime